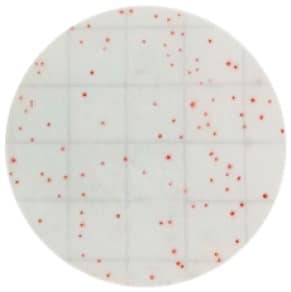
食品接觸表面清潔度檢測

食品安全上的危險溫度帶(Danger Zone)是指食品溫度處於 4°C至 60°C的溫度範圍。在這一溫度區間內,細菌和其他病原體會快速繁殖,從而導致食品腐敗或引發食源性疾病。
危害矩陣法是一種用於分析食品製程中可能存在危害的評估工具,常用於食品安全管理系統(如HACCP,危害分析重要管制點)。它通過系統性地評估潛在危害的嚴重性和發生可能性,以判定某一危害是否具有顯著性,後續再以CCP點判定步驟來決定這個步驟是否為重要管制點。